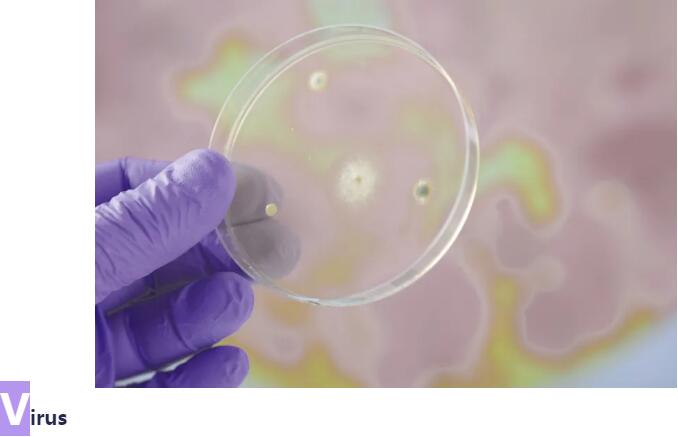

兰舍:冬季室内空气比其他季节更差?流感高发,疫情反复,升级新风应战特殊寒冬
近期气温骤降,昼夜温差大,冬季原本就是流感高发季节,加之疫情容易反复,更是让大家不敢放心呼吸。
冬季的空气质量,原本就比较差
PM2.5浓度变化呈现明显的季节性,集中供暖会增加空气中的污染颗粒浓度,同时冷空气下沉,造成空气无法上下对流,积聚的污染物很难扩散。
冬季的霾天,占比全年霾天总数近半,这时候如果开窗通风,不多时房间里就开始积灰,但即使不开窗,这些污染物也会从门窗缝隙进入家中。
人都窝在室内,更容易囤积异味
寒风呼啸,开窗通风更不现实,但长时间待在室内,呼吸不到足够的新鲜空气,胸闷气短、过敏复发、呼吸道不适等等烦人症状,也会找上身体。
室外寒冷,室内闭户,空气不能正常流通,二氧化碳浓度只升不降,采暖升温加速隐藏在涂料、地板、家具中的甲醛挥发,异味污染物囤积不散。
这个冬天尤为特殊,新冠病毒与各种流感病毒都潜伏在空气之中,让呼吸问题愈加不能被忽视,门窗紧闭的家中,需要保持新风系统24小时开启。
兰舍新风系统,不需要开窗,维持室内微正压环境,科学通风换气,阻隔室外灰尘脏空气,排出室内甲醛异味,将过滤后的新鲜空气输送全屋。

兰舍原厂滤网,由经过熔喷驻极处理的纤维合成材料制作而成,有效捕捉PM2.5、微小致敏物、细菌病毒颗粒。
可水洗康舒芯,冬季避免冷空气直接进入室内,让新风更温暖。采用高分子材料,防霉达到最高0级,抗菌率高达99.99%,可使用84消毒液清洗晾干循环使用,严防病毒细菌残留。

为应战特殊寒冬,带给用户全方位无菌守护,在原厂滤网与可水洗康舒芯之外,兰舍即将上市管道杀菌箱,可外联兰舍全系列吊顶式新风主机,进一步深层次净化室内空气。
兰舍管道杀菌箱
99.9%以上杀菌率
升级新风应战特殊寒冬
兰舍管道杀菌箱中应用有兰舍紫外线灯与光催化羟基技术,双重加持之下,对于白色葡萄球菌、大肠杆菌、金黄色葡萄球菌的杀菌效率都能达到令人惊叹的99.9%以上。

波长254nm的兰舍紫外线灯
紫外线是阳光中波长为100~400nm的光线,其中波长200~280nm的紫外线,又称为短波灭菌紫外线,能够破坏细菌病毒的遗传物质DNA的结构,使之死亡或失去繁殖能力,从而达到杀菌消毒的目的。
在短波灭菌紫外线中,又以253.7nm波长杀菌作用最强。波长254nm的兰舍紫外线灯,具备强杀菌特性,而且不会产生臭氧,使用寿命可以达到9000h以上。
兰舍工程师开发的光催化羟基技术
兰舍光催化羟基技术,所产生的净化因子(羟基),不只是能杀灭细菌病毒,还能分解甲醛、苯、二手烟等有害气体及异味,不需要后续维护保养,可以永久使用。
特别神奇的是,这是一种对细菌病毒主动进行消杀的技术,通过向全屋释放净化因子,捕捉并净化空气中的细菌病毒与其他有害物质,非常快速且不留死角。

这个冬季,就让兰舍管道杀菌箱,升级新风应战特殊寒冬,为家深层净化空气,守护家人安心呼吸。

